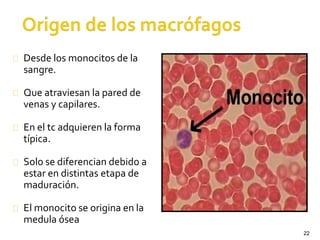
22
Desde los monocitos de la
sangre.
Que atraviesan la pared de
venas y capilares.
En el tc adquieren la forma
típica.
Solo se diferencian debido a
estar en distintas etapa de
maduración.
El monocito se origina en la
medula ósea

Este documento describe las características del tejido conectivo. Tiene múltiples funciones como soporte, transporte, relleno, almacenamiento y reparación. Contiene células fijas como fibroblastos y células móviles como macrófagos y linfocitos. La matriz extracelular incluye sustancias amorfas como ácido hialurónico y fibras como colágenas, reticulares y elásticas. El tejido conectivo cumple un papel importante en la cicatrización, defensa e inter

![LINFOCITOS (B, T [TCD4, TCD8], KILLER)
7 a10 micras pequeños y 20 micras grandes
Núcleo que llena casi toda la célula, se tiñe
intensamente de azul púrpura, rodeado de una
escasa cantidad de citoplasma de color azul de
intensidad variable, entre azul celeste y azul oscuro](https://image.slidesharecdn.com/clasetejidoconjuntivo-140729230729-phpapp02/85/Clase-tejido-conjuntivo-87-320.jpg)

